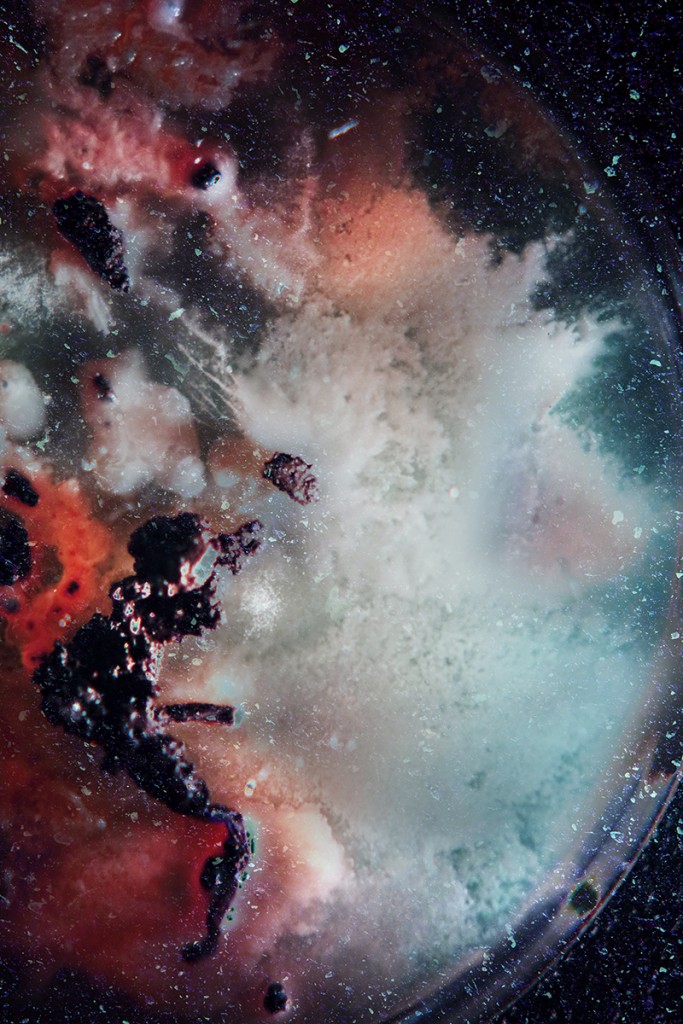
oasis_017
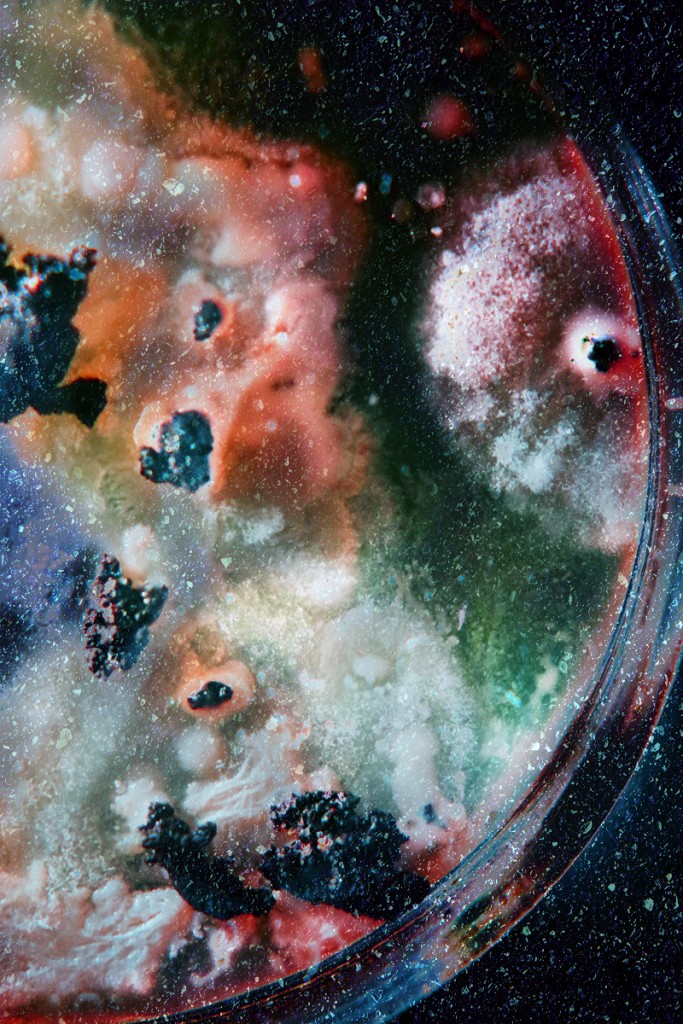
oasis_018

JP / EN
本作は、私たちの足元にある人工物に埋もれた土に着目し、人口の増加、科学技術の発達に伴い淘汰されてきた生き物たちの存在と未来の可能性について考察した。被写体として選んだのは、都市の中で、建物が取り壊された後にできる空き地である。建物が取り壊されると、その下に眠っていた土があらわになる。そこは、しばらくすると草むらになり、生き物たちが集まり、次の建物が建てられるまでの一時、都会の中のオアシスのようになる。その風景は、人類が滅んだあとの風景と、これまで埋め立ててきた多くの命の両方を想起させる。人類が引き起こした大量絶滅期の只中において、足元の土について考える事は価値があるはずだ。
本作で被写体とした空地の自然は、とはいえ、ありふれた自然である。これらの自然に改めて目を向けるため、デジタル上で写真の色を強調し、撹乱することで、普段見慣れてしまった風景を新鮮なものとして再提出した。それは同時に被写体が本来持っている力に改めて目を向けることにも繋がっている。そのため被写体の形を変えない、イメージを足したり引いたりしないということを加工のルールとした。また、それぞれの写真をアスファルトの写真によって縁取った。被写体となった場所がすでに失われてしまった事、あるいはかつて人工物に埋れていた事を示唆している。写真の下に添えられた数字はGoogle Mapの座標である。これらの場所が今後どうなって行くのかを確認することが出来るようにした。続けて、これらの写真をフイルムで複写し、そのフイルムを土に埋めた。イメージの中に人の手による加工と、自然の力の影響が混在しているような姿を見て見たいと思ったのだ。しかし、土の力は私が想像していたより強烈で、ほとんどのイメージを消し去り、残りを不鮮明にしてしまった。予期せずそれらのイメージは私たちの足元に眠る土の持つ、強烈な力を表現した。さらに、製作を進めていくうち、土そのものにも興味が湧いてきた。土は、砂や粘土、生物の遺骸や不廃物、微生物などによって構成されており、知られている限り、地球にしか存在しない。私は空き地から採取した土を培地に乗せ、微生物を培養することで目に見えない土の性質の一部を明らかにし、ミクロな視点を追加した。
本作を制作するきっかけになったのは、人間の数を減らし、生き物達に土地を譲るという少々過激でSF的な思い付きだった。そのスタートとして足元の土に思いを馳せるというのも悪くはないと思ったのだ。人間は、便利さと引き換えに多くの生き物を犠牲にしてきた。もし人類がいなくなり、人工物が劣化していき土があらわになった世界を想像するととても美しい。あるいは、私たちがこの土地を埋め立てた時、幾万の植物や、生き物たちの命が奪われ、土地を追われたことを考えるととても悲しい。あえて人工物を排して撮影された都市の中の小さな楽園の写真は、未来の地球の希望の風景であり、同時に失われた者たちの遺影でもあるのだ。私たちが道を歩いている時、足元のアスファルトの下には土があることを想像してほしい。私たちが眠っている時、私たちの家の下に土があることを想像して欲しい。この作品を通して日常生活の中に新たなパースペクティブが生まれる事を期待している。
This work focuses on soil buried under man-made objects, and considers the existence of creatures that have been eliminated due to population growth and the development of science and technology, as well as the future possibilities of the Earth. The subject is a vacant lot in a city that is created after a building is demolished. When a building is demolished, the soil sleeping underneath is revealed. After a while, the area becomes covered with grass, and creatures gather there, becoming a temporary oasis in the city until the next building is erected. The landscape evokes both the landscape after the extinction of humanity and the many lives that were buried. In the midst of a period of mass extinction caused by humans, it is surely worthwhile to think about the soil beneath our feet.
The nature of the vacant lots that were the subject of this work is, nevertheless, commonplace nature. In order to draw new attention to these places, I digitally processed the colors of the photographs, re-presenting the landscape that we are accustomed to seeing as something fresh. At the same time, this also leads to a renewed focus on the inherent power of the subjects. For this reason, the processing rules were to not change the subject’s shape, and not to add or subtract images. In addition, each photograph was framed by a photograph of asphalt. This indicates that the subjects’ locations have already been lost, or were once buried under man-made objects. The numbers attached to the photographs are Google Maps coordinates. This allows us to see what will become of these locations in the future. Next, I copied these photographs on film and buried the film in the soil. I wanted to see images that were a mixture of human processing and the influence of the power of nature. However, the power of the soil was stronger than I had imagined, erasing most of the images and making the remaining images unclear. Unexpectedly, these images expressed the intense power of the soil under our feet. Furthermore, as I continued making the work, I became interested in the soil itself. Soil is made up of sand, clay, the remains and waste of living organisms, and microorganisms, and as far as we know, it only exists on Earth. I placed soil collected from a vacant lot on agar mediums and cultivated microorganisms to reveal some of the invisible elements of soil.
What prompted me to create this work was a somewhat radical, science fiction-like idea to reduce the number of humans and give the land to living creatures. I thought it would be a good starting point to think about the soil under our feet. Humans have sacrificed many living creatures in exchange for convenience. It would be very beautiful to imagine a world where humans have disappeared, artificial objects have deteriorated, and the soil has been exposed. It’s also very sad to think that when we reclaimed this land, countless plants and living creatures lost their lives and were forced to leave their land. The photographs of a small paradise in the city, taken without artificial objects, are a landscape of hope for the future of the Earth, and at the same time, a memorial portrait of those who have been lost. I want you to imagine that there is soil under the asphalt when we walk down the street. I want you to imagine that there is soil under our houses when we sleep. I hope that this work will give rise to a new perspective in everyday life.